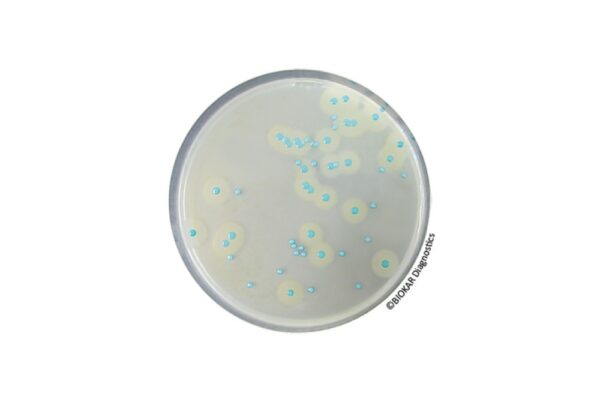
Image_TEC_INS_Biokar_Kits_Compass_1000x665_JPG Image_TEC_INS_Biokar_Kits_Compass_1000x665_JPG

Biokar – Microbiology – Kits
Biokar Diagnostics is the microbiology division of the Solabia group, dedicated to the development, production and selling of culture media, supplements and detection kits for microbiology laboratories.
Biokar Diagnostics offers specialized microbiology kits designed for the identification and enumeration of specific microorganisms in water samples.
Available Models

Baird Parker RPF (RPF = Rabbit Plasma Fibrinogen) Agar is used for the direct detection and enumeration of coagulase positive staphylococci. The medium has the advantage of considerably reducing the number of confirmation tests for the presence of coagulase positive staphylococci particularly when atypical colonies are observed on other selective media. The medium allows the simultaneous enumeration and confirmation to be performed in a single operation.
Packaging
Ready-to-use medium:
BM06708 – 20 Petri plates Ø 90 mm
BM15908 – 20 Petri plates Ø 55 mm
Kit:
BT00508 – 6 vials of 90 mL of base media and 6 RPF freeze-dried supplements
BT01008 – 6 vials of 190 mL of base media and 6 RPF freeze-dried supplements (BS075)
Dehydrated base medium:
BK055HA – 500 g bottle
BK055GC – 5 kg drum
Rabbit Plasma Fibrinogen Supplement:
BS03408 – 8 vials qsp 100 mL
BS03808 – 1 vial qsp 500 mL

COMPASS® Listeria constitutes a method constitutes a method for the detection of Listeria monocytogenes and of Listeria spp, and a method for the enumeration of Listeria monocytogenes in food products, and in environmental samples even heavily contaminated.
The method COMPASS® Listeria is used in the context of the alternative rapid method of detection of L. monocytogenes, in human food products and environmental samples.
It is characterized by one sole step in selective enrichment ½ Fraser broth, followed by a re-inoculation onto COMPASS Listeria Agar. The method is certified NF VALIDATION, under the reference N° BKR 23/02-11/02.
The method COMPASS® Listeria agar can also be used within the context of the alternative rapid method of enumeration of L. monocytogenes for all human foods and for environmental samples, by inoculation of one plate either on the surface or as a pour plate. It is officially certified by AFNOR Certification, under the reference number BKR 23/05-12/07.
Packaging
Ready-to-use medium:
BM12308 – 20 Petri plates Ø 90 mm
BM12408 – 120 Petri plates Ø 90 mm
Kit COMPASS Listeria Agar:
BT00808 – 6 vials of 200 mL base medium + 6 vials of freeze-dried selective supplement + 6 vials of liquid enrichment supplement
Dehydrated base medium:
BK192HA – 500 g bottle
Enrichment supplement:
BS07008 – 8 vials qsp 1L
Freeze-dried selective supplement:
BS07108 – 8 vials qsp 1L

IRIS Salmonella® is an alternative research method of Salmonellae in human food and feeds, and environmental sample (except primary production samples).
Studies performed on IRIS Salmonella® Agar show a high specificity for the detection of Salmonellae including atypical species and serovars, which is a source of confusion on other medium.
The detection of Salmonella Typhi and Paratyphi, lactose-positive Salmonellae (Salmonella Senftenberg and subspecies S. arizonae and S. diarizonae), saccharose-positive strains are ensured.
The media allows the detection of non-motile serovars (S. Pullorum and S. Gallinarum) or monophasic strains. IRIS Salmonella® Agar allows also the detection of strains which show a light or absence of esterasic activity on other medium (Salmonella bongori, Salmonella Dublin and Atento, certain strains of S. enterica, S. houtenae and S. diarizonae subspecies).
IRIS Salmonella® method is officially certified by AFNOR Certification, under the reference number BKR 23/07-10/11, for all human and animal food products and production and production environment samples (excluding primary production environment samples).
IRIS Salmonella® is also validated for the detection of Salmonellae in samples from 50 g to 375 g for milk powder, including infant milk with and without probiotics and from 50 g to 125 g for flours and croquettes in animal feedstuffs.
Packaging
IRIS Salmonella Agar:
BM16008 – 20 Petri plates Ø 90 mm
BM16108 – 120 Petri plates Ø 90 mm
BK212HA – 500 g bottle
Salmonella Enrichment:
BK194HA – 500 g bottle
BK194GC – 5 kg drum
BM13608 – 10 vials of 225 mL
BM13708 – 3 flexible bags of 3 L
BM14408 – 2 flexible bags of 5 L
Salmonella Enrichment + Tween® 80:
BM16308 – 3 flexible bags of 3 L
IRIS Salmonella Supplement (for Salmonella Enrichment):
BS07808 – 10 vials of 50 mL
BS07708 – 120 tablets qsp 225 mL
BS09308 – 120 tablets qsp 90 mL
Kit of Latex agglutination test:
BT01108 – CONFIRM’ Salmonella

CONFIRM’ Salmonella is a latex agglutination test that allows for the confirmation of presumed positive colonies of Salmonella, after purification.
CONFIRM’ Salmonella is also used as a means of confirmation in the context of the rapid, alternative method of Salmonella detection (IRIS Salmonella®), without a purification step, directly from a characteristic magenta colony isolated on IRIS media.
The IRIS Salmonella® method of Salmonella detection is certified by AFNOR Certification, under Attestation N° BKR 23/07 – 10/11.
Packaging
Kit:
BT01108 – Kit for 50 tests with Reagent R1 (Latex test) + Solution R2 (Positive Control) + Solution R3 (Negative Control) + disposable agglutination slides + disposable mixing batons.

EASY STAPH is an alternative method for the enumeration of coagulase positive Staphylococci in food products, in animal feeds and in environmental samples. Devoid of the need for confirmation, the method allows count of pathogenic staphylococci in 22 hours instead of the usual 48 hours in the case of the standardized method NF EN ISO 6888-2. The media support the use of surface inoculation, in depth or by the Spiral method.
For all products destined for human consumption, the method is certified NF VALIDATION, under the Attestation N°BKR 23/10 – 12/15.
Packaging
EASY STAPH ready-to-use:
BM18708 – 20 Petri plates Ø 90 mm
BM19008 – 120 Petri plates Ø 90 mm
EASY STAPH Kit:
BT01208 – 6 vials of 190 mL of base media + 6 freeze-dried supplements
BT01308 – 6 vials of 90 mL of base media + 6 freeze-dried supplements

The Microgen Listeria-ID system allows the identification of six species of Listeria (Listeria monocytogenes, Listeria ivanovii, Listeria innocua, Listeria seeligeri, Listeria grayi, Listeria welshimeri).
They employs 12 standardised substrates include the haemolysis test.
The Microgen Identification System Software is available on demand.
Packaging
Microgen Listeria-ID system Kit:
BT01408 – Complete kit for 20 tests

Microplate MUD/SF allows the practical identification and enumeration of intestinal enterococci in water, according to NF EN ISO 7899-1.
The use of microtiter plates, with wells containing a specifically developed medium, was conceived for use in the analysis of several types of water, notably swimming and beach water in salt and fresh water, surface (still) water and post-treatment water. The method is applicable to all water samples, including those rich in suspended matter. For the enumeration of enterococci, the microtiter technique with MUD has been recognized as the most specific, precise, and rapid of all previously used methods. This technique represents an important evolution as regards to existing technologies for enterococci, which among the indicator microorganisms of fecal contamination, present a particular interest in water quality controls.
Packaging
Kit MUD/SF:
BT00308 – 25 microplates + 25 sterile transparent adhesive covers

Microplate MUG/EC allows the practical identification and enumeration of Escherichia coli in water, according to ISO standard NF EN ISO 9308-3.
The use of microtiter plates, with wells containing a specifically developed medium, was conceived for use in the analysis of several types of water, notably swimming and beach water in salt and fresh water, surface (still) water and post-treatment water. The method is applicable to all water samples, including those rich in suspended matter. For the enumeration of Escherichia coli, the microtiter technique with MUG has been recognized as a more specific, precise, and rapid compared to previously used method. By virtue of its role as an indicator microorganism of fecal contamination, this bacteria is of special interest due to its exclusively intestinal origin, which confers on it a more particular status as a priority bioindicator in water quality controls.
Packaging
Kit:
BT00108 – 25 microplates + 25 sterile, transparent adhesive covers
Culture Media Production by BIOKAR Diagnostics
BIOKAR Diagnostics is an industry leader with 50 years of experience in microbiology and we got a chance to visit their factory! Follow Julien Pastor from DKSH Technology and Athanassios Giannakopoulos from BIOKAR to visit this modern factory and learn their production of culture media, from peptones to ready-to-use media.
Key Industries
- Agriculture
- Cosmetics & Personal Care
- Education & Academics
- Environmental
- Food & Beverage
- Medical
- Pharmaceutical
Biokar Diagnostics is the microbiology division of the Solabia group, dedicated to the development, production and selling of culture media,…
-
Baird Parker RPF Agar Datasheet
-
COMPASS Listeria Agar Datasheet
-
MALAYSIA
DKSH Technology Sdn. Bhd.
No. 108-B-01-08, Setia Spice Canopy, Jalan Tun Dr. Awang,
11900 Bayan Lepas, Penang
Malaysia
Download now
How to Disable Pop-Up Blockers for Smooth Downloads
Google Chrome (Version 110 and later):
- Click the three dots (menu) in the top-right corner and select Settings.
- Under Privacy and Security, click Site settings.
- Scroll down to Content and click Pop-ups and redirects.
- Toggle the switch to Allowed or add https://technology-products.dksh.com.my to the Allow list.
Mozilla Firefox (Version 90 and later):
- Click the three horizontal lines (menu) in the top-right corner and select Settings.
- Go to the Privacy & Security section.
- Scroll to Permissions and uncheck Block pop-up windows for https://technology-products.dksh.com.my.
Microsoft Edge (Version 110 and later):
- Click the three dots (menu) in the top-right corner and select Settings.
- Scroll down to Cookies and site permissions.
- Under Site permissions, click Pop-ups and redirects.
- Toggle the switch to Allow or add https://technology-products.dksh.com.my to the Allow list.
Safari (Version 14 and later):
- Open Safari and go to Preferences (from the top menu).
- Select the Websites tab.
- Under Pop-up Windows, select Allow for https://technology-products.dksh.com.my.